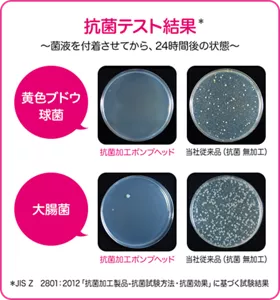

![ビオレu 泡ハンドソープ[医薬部外品]殺菌・消毒。汚れも泡もスパッとオフ!!](http://kao-h.assetsadobe3.com/is/image/content/dam/sites/kao/www-kao-co-jp/bioreu/family/hand/handsoap/mainpic.png?fmt=webp)
![ビオレu 泡ハンドソープ[医薬部外品]殺菌・消毒。汚れも泡もスパッとオフ!!](http://kao-h.assetsadobe3.com/is/image/content/dam/sites/kao/www-kao-co-jp/bioreu/family/hand/handsoap/mainpic.png?fmt=webp)
![ビオレu 泡ハンドソープ[医薬部外品]殺菌・消毒。汚れも泡もスパッとオフ!!](http://kao-h.assetsadobe3.com/is/image/content/dam/sites/kao/www-kao-co-jp/bioreu/family/hand/handsoap/mainpic@sm.png?fmt=webp)
殺菌成分配合
ウイルス・細菌を 除去
皮膚の清浄・殺菌・消毒

特長1

特長2




手の平から
こぼれにくい下向きノズル
抗菌ポンプヘッド※採用
ぐらつかず倒れにくい!安定ボトル

小さな手でも
押しやすいワイドヘッド
ビオレu Hg医薬部外品殺菌・消毒
※全ての菌に有効ではありません。ポンプヘッドは清潔に保ってください。
ビオレu バイ菌を増やしにくい抗菌ポンプヘッド※
抗菌加工のポンプヘッドは、菌を増やしにくい抗菌成分を配合し、バイ菌が少ない状態を長時間保つことができます。

※全ての菌に有効ではありません。ポンプヘッドは清潔に保ってください。
※1回分は本体内容量の約8分目です

つめかえ用2.2回分

つめかえ用4回分

つめかえ用6.2回分